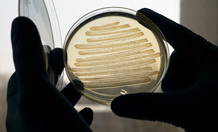

E. coli bacteria have been made to produce diesel fuel. Image credit: Marian Littlejohn
Bugs produce diesel on demand
It sounds like science fiction but a team from the University of Exeter, with support from Shell, has developed a method to make bacteria produce diesel on demand.
While the technology still faces many significant commercialisation challenges, the diesel, produced by special strains of E. coli bacteria, is almost identical to conventional diesel fuel.
This means that it does not need to be blended with petroleum products as is often required by biodiesels derived from plant oils. It also means that the diesel can be used with current supplies in existing infrastructure because engines, pipelines and tankers do not need to be modified. Biofuels with these characteristics are being termed ‘drop-ins’.
Professor John Love from Biosciences at the University of Exeter said: “Producing a commercial biofuel that can be used without needing to modify vehicles has been the goal of this project from the outset. Replacing conventional diesel with a carbon neutral biofuel in commercial volumes would be a tremendous step towards meeting our target of an 80% reduction in greenhouse gas emissions by 2050. Global demand for energy is rising and a fuel that is independent of both global oil price fluctuations and political instability is an increasingly attractive prospect.”
E. coli bacteria naturally turn sugars into fat to build their cell membranes. Synthetic fuel oil molecules can be created by harnessing this natural oil production process. Large scale manufacturing using E. coli as the catalyst is already commonplace in the pharmaceutical industry and, although the biodiesel is currently produced in tiny quantities in the laboratory, work will continue to see if this may be a viable commercial pathway to ‘drop in’ fuels.
Rob Lee from Shell Projects & Technology said: “We are proud of the work being done by Exeter in using advanced biotechnologies to create the specific hydrocarbon molecules that we know will continue to be in high demand in the future. While the technology still faces several hurdles to commercialisation, by exploring this new method of creating biofuel, along with other intelligent technologies, we hope they could help us to meet the challenges of limiting the rise in carbon dioxide emissions while responding to the growing global requirement for transport fuel.”
This work was supported by a grant from Shell Research Ltd and a Biotechnology and Biological Sciences Research Council (BBSRC) Industry Interchange Partnership Grant.
Date: 23 April 2013
